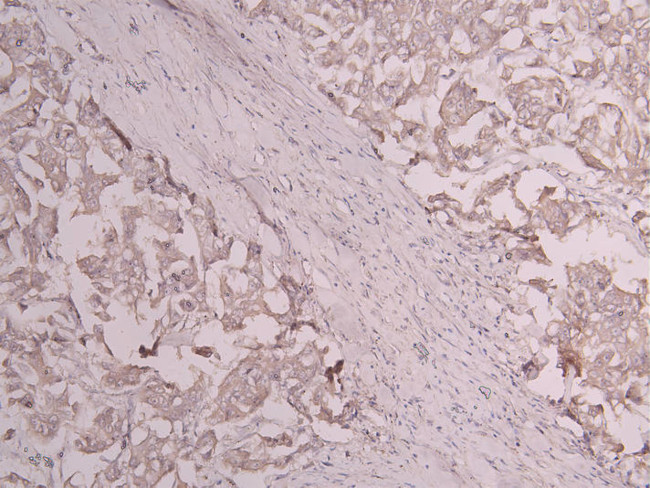
CD163 Antibody in Immunohistochemistry (Paraffin) (IHC (P))

Search
Invitrogen
CD163 Recombinant Human Monoclonal Antibody (26F9)
{{$productOrderCtrl.translations['antibody.pdp.commerceCard.promotion.promotions']}}
{{$productOrderCtrl.translations['antibody.pdp.commerceCard.promotion.viewpromo']}}
{{$productOrderCtrl.translations['antibody.pdp.commerceCard.promotion.promocode']}}: {{promo.promoCode}} {{promo.promoTitle}} {{promo.promoDescription}}. {{$productOrderCtrl.translations['antibody.pdp.commerceCard.promotion.learnmore']}}
图: 1 / 1
CD163 Antibody (MA5-60805) in IHC (P)

Please note: We are reviewing Western blot images included in the antibody testing data in our catalog, including those provided by third parties. Unless expressly labeled or annotated as “raw-unedited”, Western blot images included in the antibody testing data in our catalog may have been edited, optimized or otherwise adjusted for presentation.
产品信息
MA5-60805
种属反应
宿主/亚型
Expression System
分类
类型
克隆号
抗原
偶联物
形式
浓度
规格
纯化类型
保存液
内含物
保存条件
运输条件
RRID
靶标信息
CD163 (M130 antigen, Ber-Mac3, Ki-M8, SM4) is a 130 kDa membrane glycoprotein, a member of the scavenger receptor cysteine-rich superfamily, and a receptor for the hemoglobin-haptoglobin complex. CD163 protects tissues from free hemoglobin-mediated oxidative damage, and may play a role in the uptake and recycling of iron, via endocytosis of hemoglobin/haptoglobin and subsequent breakdown of heme. CD163 is expressed exclusively on the cell surface of human monocytes and macrophages that evolve predominantly in the late phase of inflammation. Specifically, CD163 is present on all circulating monocytes and most tissue macrophages except those found in the mantle zone and germinal centers of lymphoid follicles, interdigitating reticulum cells and Langerhan's cells. CD163 is present on all CD14 positive monocytes, most CD64 positive monocytes, and shows higher expression on CD16 positive monocytes. CD163 is upregulated on mononuclear phagocytes by IL-10, IL-6 and dexamethasone. Lipopolysaccharide (LPS) and phorbol myristate acetate (PMA) both induce shedding of CD163 from the cell surface into plasma or cell supernatant. CD163 binds hemoglobin/haptoglobin complexes in a calcium-dependent and pH-dependent manner, and exhibits a higher affinity for complexes of hemoglobin and multimeric haptoglobin of HP1F phenotype than for complexes of hemoglobin and dimeric haptoglobin of HP1S phenotype. Further, CD163 also induces a cascade of intracellular signals that involves tyrosine kinase-dependent calcium mobilization, inositol triphosphate production and secretion of IL6 and CSF1.
仅用于科研。不用于诊断过程。未经明确授权不得转售。
篇参考文献 (0)
生物信息学
蛋白别名: CD163; Hemoglobin scavenger receptor; Scavenger receptor cysteine-rich type 1 protein M130; Soluble sCD163
基因别名: CD163; M130
Entrez Gene ID: (Human) 9332